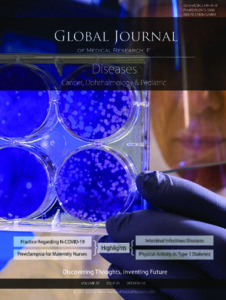
Issue Cover

Article Fingerprint
ReserarchID
17692

Covid-19 is a severe acute respiratory disease that has rapidly spread across the world originated China in December 2019. The main symptoms of a person infected with corona virus are fever, dry cough, shortness of breath, fatigue, dyspnea and myalgia. One of the main tool employed to control the pandemic is providing the community with correct information about the disease. High knowledge, right attitude towards Covid-19 and are adhering to suggested practices is the most effective approach to control community transmission. It is against this background that this study sought to assess Covid-19 knowledge, attitude and practices (KAP) among Kenyans. An online cross-section survey was used to collect data between July 26-31, 2020. From the findings, 9.1 % of the respondents indicated that their relatives, friends or themselves had contracted Covid-19. There is high knowledge of with 83.97 % (82.4,85.54) aware of its symptoms and preventative measures.
Waiguru Muriuki. 2020. \u201cAssessing Knowledge, Attitude and Practices (KAP) towards COVID19: A Cross-Sectional Study in Kenya\u201d. Global Journal of Medical Research - F: Diseases GJMR-F Volume 20 (GJMR Volume 20 Issue F10).
Crossref Journal DOI 10.17406/gjmra
Print ISSN 0975-5888
e-ISSN 2249-4618
Explore published articles in an immersive Augmented Reality environment. Our platform converts research papers into interactive 3D books, allowing readers to view and interact with content using AR and VR compatible devices.
Your published article is automatically converted into a realistic 3D book. Flip through pages and read research papers in a more engaging and interactive format.
Total Score: 105
Country: Kenya
Subject: Global Journal of Medical Research - F: Diseases
Authors: Waiguru Muriuki, Brian Muriithi, Kamande Duncan, Austin Muriuki, Grace Kihika (PhD/Dr. count: 0)
View Count (all-time): 190
Total Views (Real + Logic): 2142
Total Downloads (simulated): 1171
Publish Date: 2020 10, Mon
Monthly Totals (Real + Logic):
This study aims to comprehensively analyse the complex interplay between

Lorem ipsum dolor sit amet, consectetur adipiscing elit. Ut elit tellus, luctus nec ullamcorper mattis, pulvinar dapibus leo.





